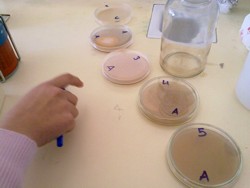
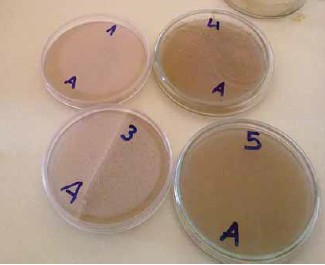

Tenemos dos salmueras:
- Una traída de la cooperativa “La Campiña”
- Otra elaborada a partir de sal, agua y un inóculo de Lactobacillus.
Tomamos muestras de las dos salmueras.
Observamos los peles de microorganismos que se han formado en el fondo de los tubos de ensayo. Se espera que la mayoría de estos microorganismos sean Lactobacillus.
Vaciamos los tubos de ensayo para quitar
el exceso de agua y los agitamos para disolver el cúmulo de microorganismos.
Tomamos muestras de los microorganismos y los observamos al microscopio.
Esta es una imagen obtenida de la muestra.
PREPARACIÓN DE LOS MEDIOS DE CULTIVO
Hemos preparado dos medios diferentes:
- Medios líquidos:
- Medio de caldo del puchero.
- Medio a partir de aceitunas trituradas
- Medios sólidos a partir de los medios líquidos.
En el documento que se redactará al acabar el trabajo encontraremos todos los detalles en el apartado: Materiales y métodos.
Medios sólidos:
- 3 placas de petri con el medio de puchero (C2, C6 y C7) y dos tubos de ensayo (C1 y C2).
- 4 placas de petri con el medio de aceitunas trituradas (A1, A3, A4 y A5) y dos tubos de ensayo (A1 y A2).
Realizamos la tinción de Gram tomando la muestra de la salmuera nueva.
Para más detalles ver apartado: Materiales y métodos en el documento final.